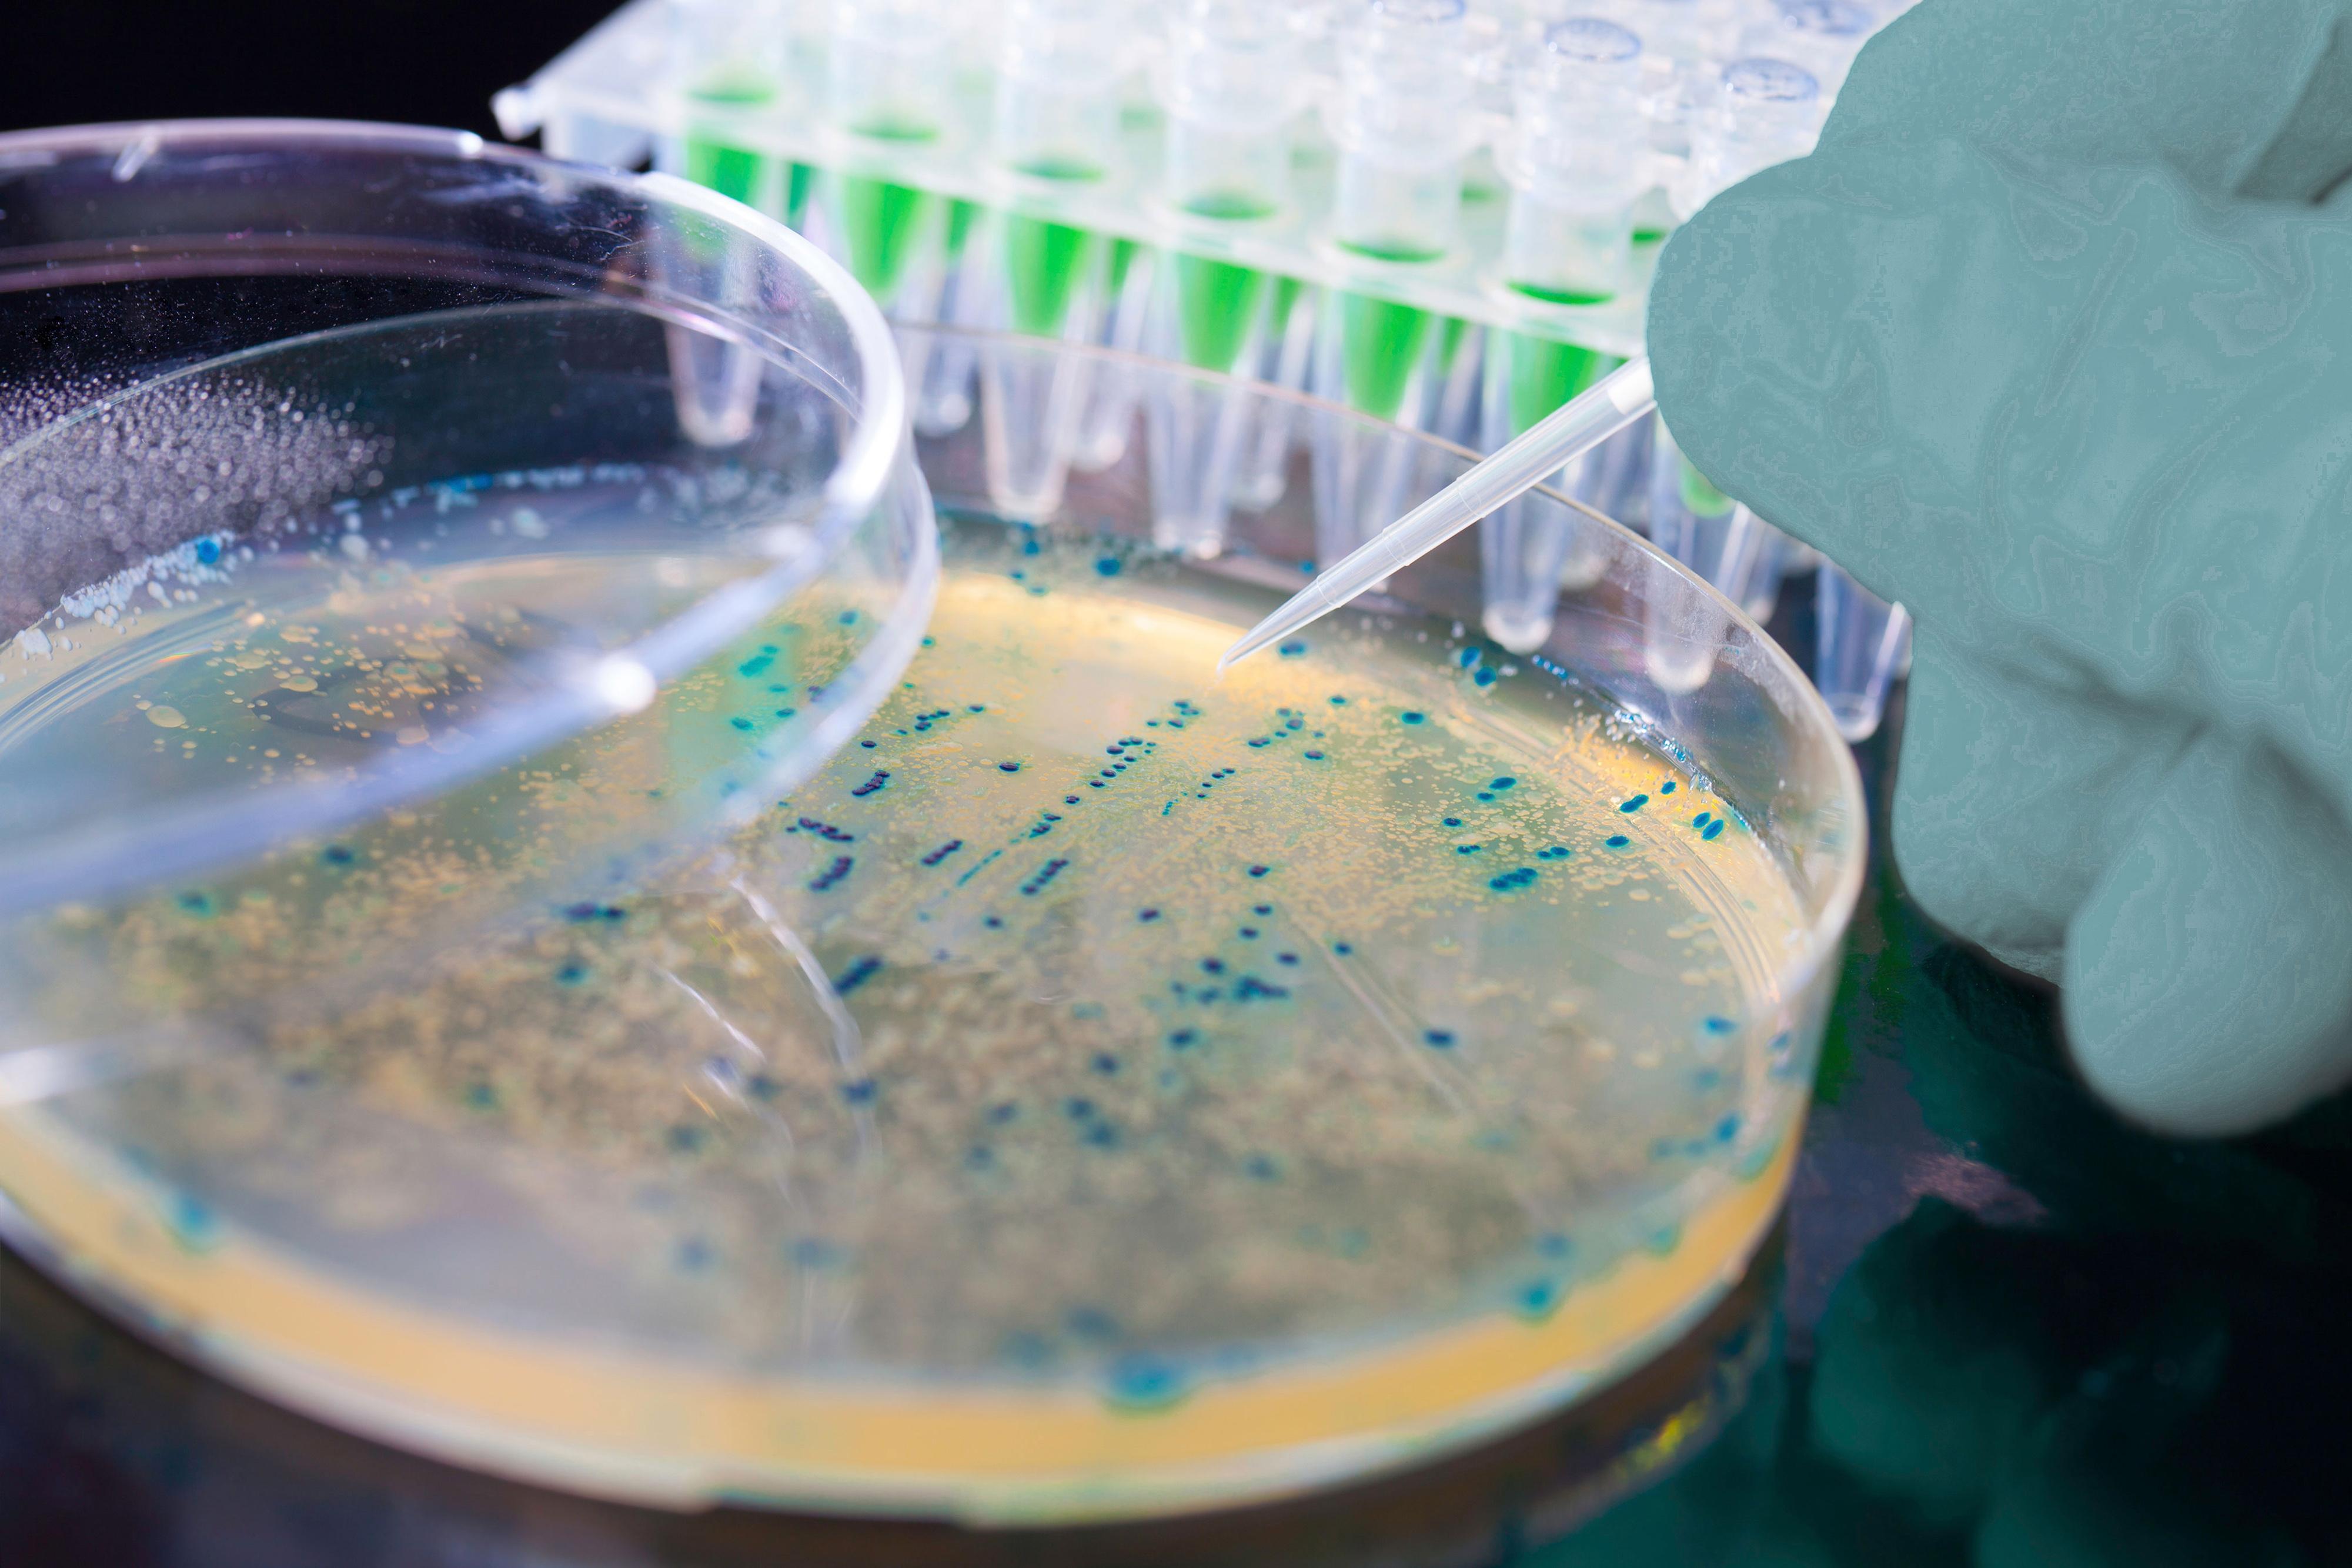

Get an overview of the three main challenges associated with infection control and reprocessing. Also, learn how sterile single-use endoscopes free up time otherwise used on reprocessing, reduce the risks of patient cross-contamination and improve patient safety.
Leading authorities recommend the transition to single-use endoscopy
There is a growing concern that, even with the most stringent high-level disinfection procedures, it is not possible to guarantee that reusable endoscopes are clean. Ambu® single-use endoscopes remove the risk of patient cross-contamination by eliminating reprocessing altogether.



The 3 main challenges of infection control in endoscopy
Complex, costly, and ultimately ineffective cleaning processes
Multiple studies have shown that regardless of the amount of resources spent and which guidelines were followed, no cleaning process effectively removes bacteria1-4. This has been true whether the reprocessing was performed using high-level disinfection (HLD), double HLD or HLD and sterilization combined5-6.
The steps below represent a condensed version of the basic recommended reprocessing actions. In reality, there can be more than 100 steps7.
Reprocessing steps:
PRE-CLEANING
CRUCIAL FOR AVOIDING BIOFILM
Important
Must be performed after procedure carefully following IFU.
LEAK TESTING
DETECT INTERNAL/EXTERNAL DAMAGE
Important
Damage can lead to inadequate disinfection & further deterioration.
MANUAL CLEANING
MOST CRITICAL STEP FOR DISINFECTION
Important
Meticulous cleaning is a prerequisite to HLD and sterilisation.
VISUAL INSPECTION
ADDITIONAL SAFETY ASSURANCE
Important
The complex design of flexible endoscopes makes it difficult to detect problems.
DISINFECTION OR STERILISATION
CRITICAL TO ADHERE TO INSTRUCTIONS
Important
The FDA recommends double HLD, or sterilisation when feasible.
STORAGE
UNDER CONDITIONS THAT PROTECT FROM MOISTURE
Important
Incorrect storage can result in bacteria growth.
DOCUMENTATION
ESSENTIAL FOR QUALITY ASSURANCE & TRACEABILITY
Important
Documentation of above steps needed each time an endoscope is reprocessed.
REPEAT PER PROCEDURE
AN ONGOING ENTERPRISE
Important
The steps shown here comprise only the basic recommended actions. Individual guidelines should be developed per institution by a multidisciplinary team.
If the margin of safety for endoscope reprocessing is so small that perfect compliance with >100 pages of the manufacturer’s instructions for use is required, then the endoscope design is too complex, the microbial load is too high, and the process is too unforgiving to be practical in the real world.7
William A. Rutala, PhD, MPHX
Endoscope design inherently difficult to clean
Long, narrow channels, difficult-to-reach areas1, 8-9 and deterioration4-5, 10-11 and grooves formed due to routine use and cleaning make endoscopes susceptible to moisture and bacterial contamination.
Bacteria can reside in the remote switches, valves of the control handle, the recesses of the distal tip, the biopsy port and the working channel of all endoscopes. In GI endoscopes, bacteria can also hide in the remote switches, valves and the wheels of the control handle, and the complex design of the duodenoscope elevator is particularly difficult to clean.
In fact, the ECRI – a non-profit US patient safety organization – has included the potential for cross-contamination and inadequate cleaning of endoscopes on their annual ECRI lists of “Top 10 Health Technology Hazards” multiple times.
Places bugs like to hide
- Bending lever
- Suction button
- Endoscope buttons
- Remote switches, valves and wheels
- Biopsy port
- Distal tip
- Distal tip with elevator
- Working channel
The rise of the superbugs
The rise in recent years of Multi-Drug Resistant Organisms (MDROs), sometimes referred to as superbugs, has made it even more challenging to clean endoscopes.12-13 For example, more than 15 reported outbreaks related to MDROs have occurred since 200014.
Ambu single-use endoscopes are sterile straight from the pack
With Ambu single-use endoscopes, you:
The fact that all Ambu single-use endoscopes are phthalate-free, one of our many environmental initiatives, also contributes to patient safety.
Learn more about single-use benefits
Discover how Ambu’s sterile single-use endoscopes provide consistently high quality and performance, help streamline workflow and give you greater cost-transparency across multiple clinical areas.
Learn about Ambu single-use endoscopes for different clinical areas
References
1. Rauwers AW, Voor in ‘t holt AF, Buijs JG, de Groot W, Erler NS, Bruno MJ, Vos MC, Nationwide risk analysis of duodenoscope and linear echoendoscope contamination, Gastrointestinal Endoscopy (2020), doi: doi.org/10.1016/j.gie.2020.05.030
2. Rex DK, Sieber M, Lehman GA, et al. A double-reprocessing high-level disinfection protocol does not eliminate positive cultures from the elevators of duodenoscopes. Endoscopy. 2018;50(6):588-596. doi:10.1055/s-0043-122378.
3. Naryzhny I, Silas D, Chi K. Impact of ethylene oxide gas sterilization of duodenoscopes after a carbapenem-resistant Enterobacteriaceae outbreak. Gastrointestinal Endoscopy (2016), doi: dx.doi.org/10.1016/j.gie.2016.01.055
4. Seidelman et al, 2021 https://www.ncbi.nlm.nih.gov/pmc/articles/PMC8111188/
5. Snyder GM, Wright SB, Smithey A, et al. Randomized Comparison of 3 High-Level Disinfection and Sterilization Procedures for Duodenoscopes. Gastroenterology. 2017;153(4):1018-1025. doi:10.1053/j.gastro.2017.06.05 2.
6. Ofstead et al., 2017: A glimpse at the true cost of reprocessing endoscopes: Results of a pilot project.
7. Kovaleva J. Infectious complications in gastrointestinal endoscopy and their prevention. Best Pract Res Clin Gastroenterol. 2016;30(5):689-704. doi:10.1016/j.bpg.2016.09.008.
8. Rutula et Al, What’s new in reprocessing endoscopes: Are we going to ensure “the needs of the patient come first” by shifting from disinfection to sterilization?, American Journal of Infection Control 47 (2019).
9. Mark J, Underberg K, Kramer R, Results of duodenoscope culture and quarantine after manufacturer-recommended cleaning process, Gastrointestinal Endoscopy (2020), doi: doi.org/10.1016/j.gie.2019.12.050
9. Gevaldá et al, 2021 https://doi.org/10.1016/j.rmed.2015.04.015
10. Ofstead CL, Wetzler HP, Heymann OL, Johnson EA, Eiland JE, Shaw MJ. Longitudinal assessment of reprocessing effectiveness for colonoscopes and gastroscopes: Results of visual inspections, biochemical markers, and microbial cultures. Am J Infect Control. 2017;45(2):e26-e33. doi:10.1016/j.ajic.2016.10.017
11. Barakat MT, Girotra M, Huang RJ, Banerjee S. Scoping the scope: endoscopic evaluation of endoscope working channels with a new high-resolution inspection endoscope (with video). Gastrointest Endosc. 2018;88(4):601-611.e1. doi:10.1016/j.gie.2018.01.018
12. Mehta AC, Muscarella LF., 2020 https://doi.org/10.1016/j.chest.2019.08.003
14. Rubin ZA, Kim S, Thaker AM, Muthusamy VR. Safely reprocessing duodenoscopes: current evidence and future directions. Lancet Gastroenterol Hepatol. 2018;3(7):499-508. doi:10.1016/S2468-1253(18)30122-5.